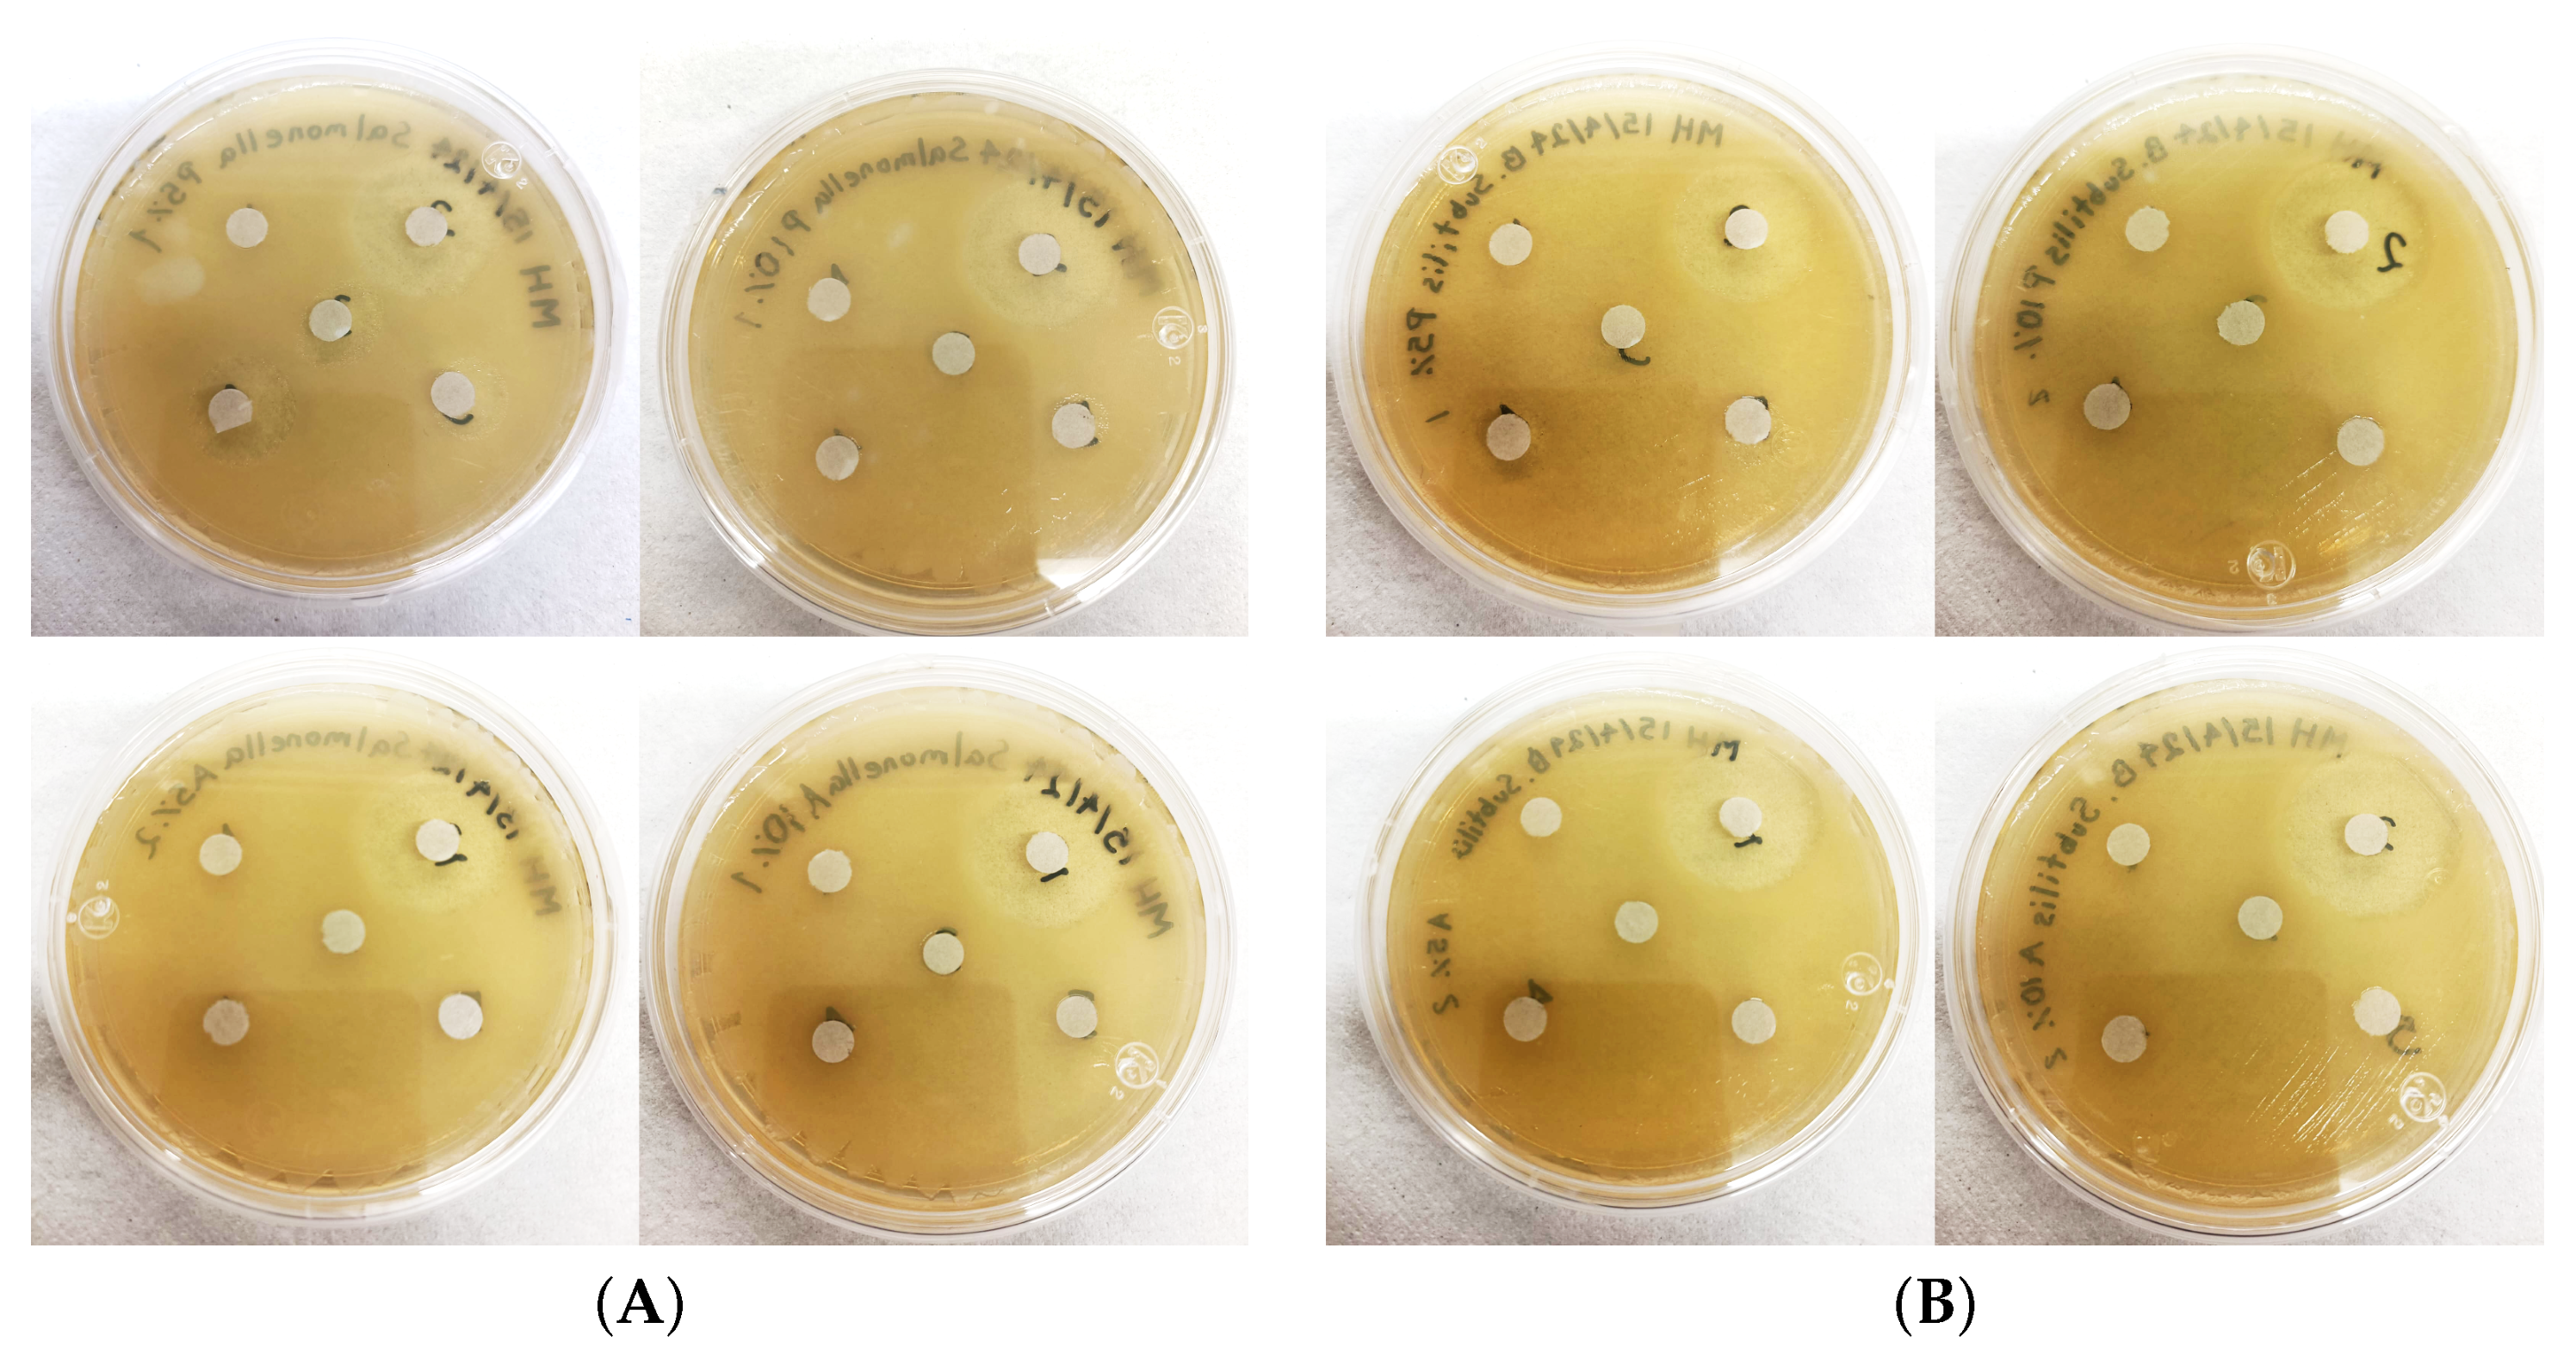
Colloids 09 00005 g008

Polydispersity and Composition Stability in a Long-Term Follow-Up of Palmarosa (Cymbopogon Martini) and Tea Tree (Melaleuca Alternifolia) O/W Nanoemulsions for Antibacterial Use
Abstract
1. Introduction
2. Materials and Methods
2.1. Materials
2.1.1. Essential Oils, Surfactant, and Continuous Phase
2.1.2. Bacterial Strains
2.2. Methods
2.2.1. Microemulsion Preparation
Initial Preparation
Ultrasonication Method
2.2.2. Composition Characterisation
2.2.3. Droplet Size Characterisation
Turbidity
Dynamic Light Scattering and Zeta Potential Measurement
Polydispersity
2.2.4. Droplet Size Stability Follow-Up
Stability of the Droplet Size Distribution
Insight Test of Thermoresponsiveness
2.2.5. Antibacterial Activity
2.2.6. Summary
3. Results
3.1. Initial Characterisation
3.1.1. Turbidity Outcomes for the Fabricated NEs
3.1.2. Composition Study After Ultrasonication
3.1.3. Initial Droplet Size Characterisation
3.2. Droplet Size Distribution Follow-Up and Its Stability
3.2.1. Long-Lived Droplet Size Stability over Time for the Emulsions
3.2.2. Initial Droplet Size Stability Behaviour Compared at Two Different EO Concentrations
3.2.3. Polydispersity Stability Analysis for the 5% NEs
3.2.4. Thermoresponsivity Insight Analysis for the Emulsions
3.2.5. Final Remarks on the Droplet Size Stability Outcomes
3.3. Antibacterial Effectiveness at Several Concentrations Including Further Dilutions
4. Discussion
4.1. Composition Study
4.2. Droplet Size and Stability Study
4.2.1. Droplet Size Follow-Up and Long-Lived Stability
4.2.2. Statistical and Physical Interpretation
4.3. Antimicrobial Properties
5. Conclusions and Future Work
Author Contributions
Funding
Data Availability Statement
Acknowledgments
Conflicts of Interest
Abbreviations
| ATR | Attenuated total reflectance |
| CAS | Chemical Abstracts Service |
| FDA | U.S. Food and Drugs Administration |
| FTIR | Fourier transform infrared spectroscopy |
| DLS | Dynamic light scattering |
| EOs | Essential oils |
| MEs | Microemulsions |
| NEs | Nanoemulsions |
| NTU | Nephelometric Turbidity Units |
| O/W | Oil in water |
| PDI | Polydispersity index |
References
- Krishnamoorthy, R.; Athinarayanan, J.; Periasamy, V.S.; Adisa, A.R.; Al-Shuniaber, M.A.; Gassem, M.A.; Alshatwi, A.A. Antimicrobial activity of nanoemulsion on drug-resistant bacterial pathogens. Microb. Pathog. 2018, 120, 85–96. [Google Scholar] [CrossRef] [PubMed]
- Dey, D.; Chowdhury, S.; Sen, R. Insight into recent advances on nanotechnology-mediated removal of antibiotic resistant bacteria and genes. J. Water Process. Eng. 2023, 52, 103535. [Google Scholar] [CrossRef]
- Mba, I.E.; Nweze, E.I. Nanoparticles as therapeutic options for treating multidrug-resistant bacteria: Research progress, challenges, and prospects. World J. Microbiol. Biotechnol. 2021, 37, 108. [Google Scholar] [CrossRef] [PubMed]
- Weisany, W.; Yousefi, S.; Razzak Tahir, N.A.; Golestanehzadeh, N.; McClements, D.J.; Adhikari, B.; Ghasemlou, M. Targeted delivery and controlled released of essential oils using nanoencapsulation: A review. Adv. Colloid Interface Sci. 2022, 303, 102655. [Google Scholar] [CrossRef]
- Wang, Y.; Ai, C.; Wang, H.; Chen, C.; Teng, H.; Xiao, J.; Chen, L. Emulsion and its application in the food field: An update review. eFood 2023, 4, e102. [Google Scholar] [CrossRef]
- Ozogul, Y.; Karsli, G.T.; Durmuş, M.; Yazgan, H.; Oztop, H.M.; McClements, D.J.; Ozogul, F. Recent developments in industrial applications of nanoemulsions. Adv. Colloid Interface Sci. 2022, 304, 102685. [Google Scholar] [CrossRef]
- Mushtaq, A.; Wani, S.M.; Malik, A.R.; Gull, A.; Ramniwas, S.; Nayik, G.A.; Ercisli, S.; Marc, R.A.; Ullah, R.; Bari, A. Recent insights into Nanoemulsions: Their preparation, properties and applications. Food Chem. X 2023, 18, 100684. [Google Scholar] [CrossRef]
- Ashaolu, T.J. Nanoemulsions for health, food, and cosmetics: A review. Environ. Chem. Lett. 2021, 19, 3381–3395. [Google Scholar] [CrossRef]
- Gupta, A.; Eral, H.B.; Hatton, T.A.; Doyle, P.S. Nanoemulsions: Formation, properties and applications. Soft Matter 2016, 12, 2826–2841. [Google Scholar] [CrossRef]
- Jafari, S.; McClements, D. Nanoemulsions: Formulation, Applications, and Characterization; Elsevier Science: Amsterdam, The Netherlands, 2018. [Google Scholar]
- Naseema, A.; Kovooru, L.; Behera, A.K.; Kumar, K.P.; Srivastava, P. A critical review of synthesis procedures, applications and future potential of nanoemulsions. Adv. Colloid Interface Sci. 2021, 287, 102318. [Google Scholar] [CrossRef]
- Czerniel, J.; Gostyńska, A.; Jańczak, J.; Stawny, M. A critical review of the novelties in the development of intravenous nanoemulsions. Eur. J. Pharm. Biopharm. 2023, 191, 36–56. [Google Scholar] [CrossRef] [PubMed]
- Touayar, M.; Zayani, R.; Messaoud, C.; Salman, H. Infuence of droplet size on the antibacterial efcacy of citral and citronella oil nanoemulsions in polysaccharide coated fresh-cut apples. Sci. Rep. 2023, 13, 10460. [Google Scholar] [CrossRef] [PubMed]
- Wilson, R.J.; Li, Y.; Yang, G.; Zhao, C.X. Nanoemulsions for drug delivery. Particuology 2022, 64, 85–97. [Google Scholar] [CrossRef]
- Aljabri, N.M.; Shi, N.; Cavazos, A. Nanoemulsion: An emerging technology for oilfield applications between limitations and potentials. J. Pet. Sci. Eng. 2022, 208, 109306. [Google Scholar] [CrossRef]
- McClements, D.J. Advances in edible nanoemulsions: Digestion, bioavailability, and potential toxicity. Prog. Lipid Res. 2021, 81, 101081. [Google Scholar] [CrossRef]
- Shiyu, H.; Jiaxuan, C.; Yeting, Z.; Yelu, W.; Tongtong, D.; Hangyan, S. Preparation of Stable Microemulsions with Different Droplet Size. Am. J. Nanosci. 2019, 5, 76–82. [Google Scholar] [CrossRef]
- Kumar, N.; Verma, A.; Mandal, A. Formation, characteristics and oil industry applications of nanoemulsions: A review. J. Pet. Sci. Eng. 2021, 206, 109042. [Google Scholar] [CrossRef]
- Sneha, K.; Kumar, A. Nanoemulsions: Techniques for the preparation and the recent advances in their food applications. Innov. Food Sci. Emerg. Technol. 2022, 76, 102914. [Google Scholar] [CrossRef]
- Choi, S.J.; McClements, D.J. Nanoemulsions as delivery systems for lipophilic nutraceuticals: Strategies for improving their formulation, stability, functionality and bioavailability. Food Sci. Biotechnol. 2020, 29, 149–168. [Google Scholar] [CrossRef]
- Gauthier, G.; Capron, I. Pickering nanoemulsions: An overview of manufacturing processes, formulations, and applications. JCIS Open 2021, 4, 100036. [Google Scholar] [CrossRef]
- Kumar, M.; Bishnoi, R.S.; Shukla, A.K.; Jain, C.P. Techniques for Formulation of Nanoemulsion Drug Delivery System: A Review. Prev. Nutr. Food Sci. 2019, 24, 225–234. [Google Scholar] [CrossRef] [PubMed]
- Nazzaro, F.; Fratianni, F.; Martino, L.D.; Coppola, R.; Feo, V.D. Effect of Essential Oils on Pathogenic Bacteria. Pharmaceuticals 2013, 6, 1451. [Google Scholar] [CrossRef]
- Rodrigue, K.C.T.; Djouhou, M.C.; Koudoro, Y.A.; Dahouenon-Ahoussi, E.; Avlessi, F.; Koko, C.; Sohounhloue, D.; Simal-Gandara, J. Essential oils as natural antioxidants for the control of food preservation. Food Chem. Adv. 2023, 2, 100312. [Google Scholar] [CrossRef]
- Santamarta, S.; Aldavero, A.C.; Rojo, M.A. Essential oil of Cymbopogon martini, source of geraniol, as a potential antibacterial agent against Bacillus subtilis, a pathogen of the bakery industry. F1000Research 2023, 10, 1027. [Google Scholar] [CrossRef] [PubMed]
- Abdi-Moghadam, Z.; Mazaheri, Y.; Rezagholizade-shirvan, A.; Mahmoudzadeh, M.; Sarafraz, M.; Mohtashami, M.; Shokri, S.; Ghasemi, A.; Nickfar, F.; Darroudi, M.; et al. The significance of essential oils and their antifungal properties in the food industry: A systematic review. Heliyon 2023, 9, e21386. [Google Scholar] [CrossRef]
- da Rocha Neto, A.C.; Navarro, B.B.; Canton, L.; Maraschin, M.; Di Piero, R.M. Antifungal activity of palmarosa (Cymbopogon martinii), tea tree (Melaleuca alternifolia) and star anise (Illicium verum) essential oils against Penicillium expansum and their mechanisms of action. LWT 2019, 105, 385–392. [Google Scholar] [CrossRef]
- Revathi, D.; Jaganathan, D.; Sivamani, P.; Arassu, R.R.T. Antifungal activity of palmarosa and geranuim, the natural essential oils against isolates from household refrigerators. Int. J. Curr. Sci. 2012, 2012, 58–66. [Google Scholar]
- Carson, C.F.; Hammer, K.A.; Riley, T.V. Melaleuca alternifolia (Tea Tree) Oil: A Review of Antimicrobial and Other Medicinal Properties. Clin. Microbiol. Rev. 2006, 19, 50. [Google Scholar] [CrossRef]
- Gemeda, N.; Tadele, A.; Lemma, H.; Girma, B.; Addis, G.; Tesfaye, B.; Abebe, A.; Gemechu, W.; Yirsaw, K.; Teka, F.; et al. Development, Characterization, and Evaluation of Novel Broad-Spectrum Antimicrobial Topical Formulations from Cymbopogon martini(Roxb.) W. Watson Essential Oil. Evid.-Based Complement. Altern. Med. 2018, 2018, 9812093. [Google Scholar] [CrossRef]
- Simirgiotis, M.J.; Burton, D.; Parra, F.; López, J.; Muñoz, P.; Escobar, H.; Parra, C. Antioxidant and Antibacterial Capacities of Origanum vulgare L. Essential Oil from the Arid Andean Region of Chile and its Chemical Characterization by GC-MS. Metabolites 2020, 10, 414. [Google Scholar] [CrossRef]
- Kim, S.; Lee, S.; Li, S. The Effect of Essential Oils from Tea-tree and Palmarosa on the Acne Skin. Asian J. Beauty Cosmetol. 2013, 11, 1083–1090. [Google Scholar]
- Sinha, S.; Biswas, D.; Mukherjee, A. Antigenotoxic and antioxidant activities of palmarosa and citronella essential oils. J. Ethnopharmacol. 2011, 137, 1521–1527. [Google Scholar] [CrossRef] [PubMed]
- Jesser, E.; Yeguerman, C.; Gili, V.; Santillan, G.; Murray, A.P.; Domini, C.; Werdin-González, J.O. Optimization and Characterization of Essential Oil Nanoemulsions Using Ultrasound for New Ecofriendly Insecticides. Sustain. Chem. Eng. 2020, 8, 7981–7992. [Google Scholar] [CrossRef]
- Prashar, A.; Hili, P.; Veness, R.G.; Evans, C.S. Antimicrobial action of palmarosa oil (Cymbopogon martinii) on Saccharomyces cerevisiae. Phytochemistry 2003, 63, 569–575. [Google Scholar] [CrossRef]
- Salvia-Trujillo, L.; Rojas-Graü, A.; Soliva-Fortuny, R.; Martín-Belloso, O. Physicochemical characterization and antimicrobial activity of food-grade emulsions and nanoemulsions incorporating essential oils. Food Hydrocoll. 2015, 43, 547–556. [Google Scholar] [CrossRef]
- Wei, S.; Tian, Q.; Zhao, X.; Liu, X.; Husien, H.M.; Liu, M.; Li, J. Tea Tree Oil Nanoemulsion Potentiates Antibiotics against Multidrug-Resistant Escherichia coli. ACS Infect. Dis. 2022, 8, 1618–1626. [Google Scholar] [CrossRef]
- Castro, J.C.; Pante, G.C.; de Souza, D.S.; Pires, T.Y.; Miyoshi, J.H.; Garcia, F.P.; Nakamura, C.V.; Mulati, A.C.N.; Mossini, S.A.G.; Junior, M.M.; et al. Molecular inclusion of Cymbopogon martinii essential oil with β-cyclodextrin as a strategy to stabilize and increase its bioactivity. Food Hydrocoll. Health 2022, 2, 100066. [Google Scholar] [CrossRef]
- Lira, M.H.P.D.; de Andrade Júnior, F.P.; Moraes, G.F.Q.; da Silva Macena, G.; de Oliveira Pereira, F.; Lima, I.O. Antimicrobial activity of geraniol: An integrative review. J. Essent. Oil Res. 2020, 32, 187–197. [Google Scholar] [CrossRef]
- Cox, S.D.; Mann, C.M.; Markham, J.L.; Gustafson, J.E.; Warmington, J.R.; Wyllie, S.G. Determining the Antimicrobial Actions of Tea Tree Oil. Mol. J. Synth. Chem. Nat. Prod. Chem. 2001, 6, 87. [Google Scholar] [CrossRef]
- Maurya, A.; Singh, V.K.; Das, S.; Prasad, J.; Kedia, A.; Upadhyay, N.; Dubey, N.K.; Dwivedy, A.K. Essential Oil Nanoemulsion as Eco-Friendly and Safe Preservative: Bioefficacy Against Microbial Food Deterioration and Toxin Secretion, Mode of Action, and Future Opportunities. Front. Microbiol. 2021, 12, 751062. [Google Scholar] [CrossRef]
- FDA Center for Drug Evaluation and Research. Inactive Ingredient Search for Approved Drug Products; U.S. Food & Drug Administration: Silver Spring, MD, USA, 2023. [Google Scholar]
- Dávila-Rodríguez, M.; López-Malo, A.; Palou, E.; Ramírez-Corona, N.; Jiménez-Munguía, M.T. Essential oils microemulsions prepared with high-frequency ultrasound: Physical properties and antimicrobial activity. J. Food Sci. Technol. 2020, 57, 4133–4142. [Google Scholar] [CrossRef] [PubMed]
- Karunaratne, D.N.; Pamunuwa, G.; Ranatunga, U. Introductory Chapter: Microemulsions. In Properties and Uses of Microemulsions; Karunaratne, D.N., Pamunuwa, G., Ranatunga, U., Eds.; IntechOpen: Rijeka, Croatia, 2017; Chapter 1; pp. 2–12. [Google Scholar] [CrossRef]
- Marinković, J.; Bošković, M.; Tasić, G.; Vasilijević, B.; Marković, D.; Marković, T.; Nikolić, B. Cymbopogon martinii essential oil nanoemulsions: Physico-chemical characterization, antibacterial and antibiofilm potential against Enterococcus faecalis. Ind. Crops Prod. 2022, 187, 115478. [Google Scholar] [CrossRef]
- Falleh, H.; Jemaa, M.B.; Neves, M.A.; Isoda, H.; Nakajima, M.; Ksouri, R. Peppermint and Myrtle nanoemulsions: Formulation, stability, and antimicrobial activity. LWT 2021, 152, 112377. [Google Scholar] [CrossRef]
- Nirmal, N.P.; Mereddy, R.; Li, L.; Sultanbawa, Y. Formulation, characterisation and antibacterial activity of lemon myrtle and anise myrtle essential oil in water nanoemulsion. Food Chem. 2018, 254, 1–7. [Google Scholar] [CrossRef]
- Schulze, H. Schwefelarsen in wässriger Lösung. J. Prakt. Chem. 1882, 25, 431–452. [Google Scholar] [CrossRef]
- Hardy, W.B.; Neville, F.H. A preliminary investigation of the conditions which determine the stability of irreversible hydrosols. Proc. R. Soc. Lond. 1900, 66, 110–125. [Google Scholar] [CrossRef]
- Malvern Instruments Ltd. Zetasizer Nano User Manual; Malvern Instruments Ltd.: Malvern, UK, 2013. [Google Scholar]
- Anarjan, N.; Tan, C.P. Developing a three component stabilizer system for producing astaxanthin nanodispersions. Food Hydrocoll. 2013, 30, 437–447. [Google Scholar] [CrossRef]
- Patravale, V.B.; Date, A.A.; Kulkarni, R.M. Nanosuspensions: A promising drug delivery strategy. J. Pharm. Pharmacol. 2004, 56, 827–840. [Google Scholar] [CrossRef]
- Gibis, M.; Rahn, N.; Weiss, J. Physical and Oxidative Stability of Uncoated and Chitosan-Coated Liposomes Containing Grape Seed Extract. Pharmaceutics 2013, 5, 421–433. [Google Scholar] [CrossRef]
- Kahlweit, M.; Strey, R.; Busse, G. Microemulsions: A qualitative thermodynamic approach. J. Phys. Chem. 1990, 94, 3881–3894. [Google Scholar] [CrossRef]
- Anton, N.; Vandamme, T. Nano-emulsions and Micro-emulsions: Clarifications of the Critical Differences. Pharm. Res. 2011, 28, 978–985. [Google Scholar] [CrossRef] [PubMed]
- van Oss, C.J. Interfacial Phenomena in Apolar Media (Surfactant Science Series Vol. 21). H.F. Eicke and G.D. Parfitt, eds. Marcel Dekker, Inc., New York and Basel, 1987, pp ix + 416, $99.75. J. Dispers. Sci. Technol. 1990, 11, 435–436. [Google Scholar] [CrossRef]
- Koroleva, Y.; Yurtovm, E. Nanoemulsions: The properties, methods of preparation and promising applications. Russ. Chem. Rev. 2012, 81, 21–43. [Google Scholar] [CrossRef]
- Hategekimana, J.; Chamba, M.V.; Shoemaker, C.F.; Majeed, H.; Zhong, F. Vitamin E nanoemulsions by emulsion phase inversion: Effect of environmental stress and long-term storage on stability and degradation in different carrier oil types. Colloids Surfaces Physicochem. Eng. Asp. 2015, 483, 70–80. [Google Scholar] [CrossRef]
- Erramreddy, V.V.; Tu, S.; Ghosh, S. Rheological reversibility and long-term stability of repulsive and attractive nanoemulsion gels. RSC Adv. 2017, 7, 47818–47832. [Google Scholar] [CrossRef]
- Liu, L.; Niu, J.; Wu, J.Y. Development of highly stable paraffin wax/water phase change material nano-emulsions as potential coolants for thermal management. Sol. Energy Mater. Sol. Cells 2023, 252, 112184. [Google Scholar] [CrossRef]
- Uluata, S.; McClements, D.J. Physical Stability, Autoxidation, and Photosensitized Oxidation of ω-3 Oils in Nanoemulsions Prepared with Natural and Synthetic Surfactants. J. Agric. Food Chem. 2015, 63, 933–9340. [Google Scholar] [CrossRef]
- Hashemnejad, S.M.; Zarket, B.; Ricardo Castaneda, C.; Doyle, P.S. Thermoresponsive nanoemulsion-based gel synthesized through a low-energy process. Nat. Commun. 2019, 10, 2749. [Google Scholar] [CrossRef]
- Silhavy, T.J.; Kahne, D.; Walker, S. The Bacterial Cell Envelope. Cold Spring Harb. Perspect. Biol. 2010, 2, 414. [Google Scholar] [CrossRef]
- Hashem, A.H.; Doghish, A.S.; Ismail, A.; Hassanin, M.M.; Okla, M.K.; Saleh, I.A.; AbdElgawad, H.; Shehabeldine, A.M. A novel nanoemulsion based on clove and thyme essential oils: Characterization, antibacterial, antibiofilm and anticancer activities. Electron. J. Biotechnol. 2024, 68, 20–30. [Google Scholar] [CrossRef]
- Linke, C.; Drusch, S. Turbidity in oil-in-water-emulsions — Key factors and visual perception. Food Res. Int. 2016, 89, 202–210. [Google Scholar] [CrossRef] [PubMed]
- Čilek, A.; Čelebi, N.; Tirnaksiz, F. Lecithin-Based Microemulsion of a Peptide for Oral Administration: Preparation, Characterization, and Physical Stability of the Formulation. Drug Deliv. 2006, 13, 19–24. [Google Scholar] [CrossRef] [PubMed]
- Aldrich Chemical Company. Catalog Handbook of Fine Chemicals; Aldrich Chemical Company: Milwaukee, WI, USA, 1990. [Google Scholar]
- Berechet, M.D.; Chirilă, C.; Simion, D.; Niculescu, O.; Stanca, M.; Alexe, C.A.; Chelaru, C.; Râpă, M.; Gurău, D.F. Antifungal Activity of Leather Treated with Anethum graveolens and Melaleuca alternifolia Essential Oils against Trichophyton interdigitale. Leather Footwear J. 2020, 20, 133–144. [Google Scholar] [CrossRef]
- Sanchez-Gaitan, E.; González-López, V.; Delgado, F. Characterization data FTIR and DLS for Palmarosa and Tea Tree nanoemulsions at 5% and 10%. Mendeley Data 2024, 1. [Google Scholar] [CrossRef]
- Sarheed, O.; Dibi, M.; Ramesh, K.V.R.N.S. Studies on the Effect of Oil and Surfactant on the Formation of Alginate-Based O/W Lidocaine Nanocarriers Using Nanoemulsion Template. Pharmaceutics 2020, 12, 1223. [Google Scholar] [CrossRef]
- Kepekçi, R.A.; İlçe, B.Y.; Kanmazalp, S.D. Plant-derived biomaterials for wound healing. In Bioactive Natural Products; ur Rahman, A., Ed.; Elsevier: Amsterdam, The Netherlands, 2021; Volume 70, pp. 227–264. [Google Scholar]
- Gohel, M.; Soni, T.; Hingorani, L.; Patel, A.; Patel, N. Development and Optimization of Plant Extract Loaded Nanoemulsion Mixtures for the Treatment of Inflammatory Disorder. Curr. Res. Drug Discov. 2015, 1, 29–38. [Google Scholar] [CrossRef]
- Maharini, I.; Utami, D.T.; Fitrianingsih. The Influence of Tween 80 in The Formulation of Nanoemulsion Virgin Coconut Oil. In International Conference on Pharmaceutical Research and Practice 2018; Universitas Islam Indonesia: Kota Depok, Indonesia, 2018; pp. 75–78. [Google Scholar]
- Cortés, H.; Hernández-Parra, H.; Bernal-Chávez, S.A.; Prado-Audelo, M.L.D.; Caballero-Florán, I.H.; Borbolla-Jiménez, F.V.; González-Torres, M.; Magaña, J.J.; Leyva-Gómez, G. Non-Ionic Surfactants for Stabilization of Polymeric Nanoparticles for Biomedical Uses. Materials 2021, 14, 3197. [Google Scholar] [CrossRef]
- Hunter, R.J. Influence of More Complex Adsorbates on Zeta Potential. In Zeta Potential in Colloid Science; Academic Press: Cambridge, MA, USA, 1981; pp. 305–344. [Google Scholar]
- Bhatt, N.; Prasad, R.K.; Singh, K.; Panpalia, G.M. Stability study of O/W emulsions using zeta potential. J. Chem. Pharm. Res. 2010, 2, 512–527. [Google Scholar]
- McClements, D.J. Nanoemulsions versus microemulsions: Terminology, differences, and similarities. Soft Matter 2012, 8, 1719–1729. [Google Scholar] [CrossRef]
- Fryd, M.M.; Mason, T.G. Time-Dependent Nanoemulsion Droplet Size Reduction By Evaporative Ripening. Phys. Chem. Lett. 2010, 1, 3349–3353. [Google Scholar] [CrossRef]
- Park, J.; Kim, S.; Chang, Y.; Imm, J.Y. Synergistic antimicrobial effect and mode of action of palmarosa oil-loaded nanoemulsion and citric acid against Pectobacterium carotovorum. Food Sci. Biotechnol. 2023, 32, 823–831. [Google Scholar] [CrossRef] [PubMed]
- Hombach, M.; Ochoa, C.; Maurer, F.P.; Pfiffner, T.; Böttger, E.C.; Furrer, R. Relative contribution of biological variation and technical variables to zone diameter variations of disc diffusion susceptibility testing. J. Antimicrob. Chemother. 2016, 71, 141–151. [Google Scholar] [CrossRef] [PubMed]
- Doghish, A.S.; Shehabeldine, A.M.; El-Mahdy, H.A.; Hassanin, M.M.; Al-Askar, A.A.; Marey, S.A.; AbdElgawad, H.; Hashem, A.H. Thymus Vulgaris Oil Nanoemulsion: Synthesis, Characterization, Antimicrobial and Anticancer Activities. Molecules 2023, 28, 6910. [Google Scholar] [CrossRef] [PubMed]
- da Silva, B.D.; do Rosário, D.K.A.; Neto, L.T.; Lelis, C.A.; Conte-Junior, C.A. Antioxidant, Antibacterial and Antibiofilm Activity of Nanoemulsion-Based Natural Compound Delivery Systems Compared with Non-Nanoemulsified Versions. Foods 2023, 12, 1901. [Google Scholar] [CrossRef] [PubMed]
- Nazıroğlu, M.; Öznur, D.; Öznur, Ö.; Diler, A. In vitro antibacterial activity of Origanum onites and Mentha spicata subs tomentosa essential oil nanoemulsions against bacterial fish pathogens. Acta Aquat. Turc. 2022, 18, 495–504. [Google Scholar] [CrossRef]
- Alkhatib, M.H.; Al-Husini, F.S.; Al-Amri, M.Y.; Al-Hatmi, A.; Al-Riyami, K.O.; Al-Ghafri, M.S. Antimicrobial Activity of Chitosan-vitamin E-Nanoemulsion. J. Microbiol. Biotechnol. Food Sci. 2023, 13, e10123. [Google Scholar] [CrossRef]
- Kakaraparthi, P.S.; Srinivas, K.; Kumar, J.K.; Kumar, A.N.; Rajput, D.K.; Anubala, S. Changes in the essential oil content and composition of palmarosa (Cymbopogon martini) harvested at different stages and short intervals in two different seasons. Ind. Crop. Prod. 2015, 69, 348–354. [Google Scholar] [CrossRef]
- Goddeeris, C.; Cuppo, F.; Reynaers, H.; Bouwman, W.; den Mooter, G.V. Light Scattering Measurements on Microemulsions: Estimation of Droplet Sizes. Int. J. Pharm. 2006, 312, 187–195. [Google Scholar] [CrossRef]
- Thao Minh Ho, F.A.; Mikkonen, K.S. An overview of nanoemulsion characterization via atomic force microscopy. Crit. Rev. Food Sci. Nutr. 2022, 62, 4908–4928. [Google Scholar] [CrossRef] [PubMed]

| EO | Conc. | Turbidity (NTU) | Av. Size (nm) | |
|---|---|---|---|---|
| Palmarosa | 5% | 34.6 | 11.4 | 0.23 |
| 10% | 53.5 | 14.7 | 0.52 | |
| Tea tree | 5% | 33.8 | 10.9 | 0.16 |
| 10% | 50.6 | 16.9 | 1.51 |
| EO | Time | Max. (nm) | (nm) | (nm) | PDIa | PDIb | (mV) |
|---|---|---|---|---|---|---|---|
| Palmarosa | Initial | 10.37 | 11.45 | 3.15 | 0.28 | 0.23 | −1.08 |
| 1 month | 9.76 | 10.87 | 3.19 | 0.29 | 0.21 | −1.09 | |
| 3 months | 9.66 | 10.81 | 3.13 | 0.29 | 0.19 | −1.09 | |
| 6 months | 8.64 | 9.85 | 3.01 | 0.31 | 0.18 | −1.12 | |
| 1 year | 8.82 | 9.94 | 3.00 | 0.30 | 0.18 | −1.11 | |
| Tea tree | Initial | 9.76 | 10.88 | 3.26 | 0.30 | 0.16 | −2.11 |
| 1 month | 10.47 | 11.58 | 3.24 | 0.28 | 0.18 | −2.31 | |
| 3 months | 9.46 | 10.49 | 3.00 | 0.29 | 0.18 | −2.46 | |
| 6 months | 7.42 | 8.49 | 2.60 | 0.31 | 0.24 | −2.67 | |
| 1 year | 7.65 | 8.57 | 2.48 | 0.29 | 0.22 | −2.95 |
| Bacteria | S | ||||
|---|---|---|---|---|---|
| Blank | 0.67 | 0.68 | 0.66 | 0.66 | |
| Salmonella spp. | AB | 2.56 | 2.55 | 2.50 | 2.54 |
| NE | 1.39 | 0.92 | 0.78 | 0.77 | |
| 50% | 1.57 | 0.73 | 0.81 | 0.81 | |
| 25% | 1.06 | 1.05 | 0.72 | 0.68 | |
| Blank | 0.66 | 0.68 | 0.66 | 0.66 | |
| AB | 2.62 | 2.56 | 2.56 | 2.68 | |
| B. subtilis | NE | 1.06 | 0.78 | 0.80 | 0.81 |
| 50% | 0.89 | 0.73 | 0.76 | 0.71 | |
| 25% | 0.88 | 0.71 | 0.73 | 0.71 |
Disclaimer/Publisher’s Note: The statements, opinions and data contained in all publications are solely those of the individual author(s) and contributor(s) and not of MDPI and/or the editor(s). MDPI and/or the editor(s) disclaim responsibility for any injury to people or property resulting from any ideas, methods, instructions or products referred to in the content. |
© 2025 by the authors. Licensee MDPI, Basel, Switzerland. This article is an open access article distributed under the terms and conditions of the Creative Commons Attribution (CC BY) license (https://creativecommons.org/licenses/by/4.0/).
Share and Cite
Sánchez-Gaitán, E.; González-López, V.; Delgado, F. Polydispersity and Composition Stability in a Long-Term Follow-Up of Palmarosa (Cymbopogon Martini) and Tea Tree (Melaleuca Alternifolia) O/W Nanoemulsions for Antibacterial Use. Colloids Interfaces 2025, 9, 5. https://doi.org/10.3390/colloids9010005
Sánchez-Gaitán E, González-López V, Delgado F. Polydispersity and Composition Stability in a Long-Term Follow-Up of Palmarosa (Cymbopogon Martini) and Tea Tree (Melaleuca Alternifolia) O/W Nanoemulsions for Antibacterial Use. Colloids and Interfaces. 2025; 9(1):5. https://doi.org/10.3390/colloids9010005
Chicago/Turabian StyleSánchez-Gaitán, Erick, Vianney González-López, and Francisco Delgado. 2025. "Polydispersity and Composition Stability in a Long-Term Follow-Up of Palmarosa (Cymbopogon Martini) and Tea Tree (Melaleuca Alternifolia) O/W Nanoemulsions for Antibacterial Use" Colloids and Interfaces 9, no. 1: 5. https://doi.org/10.3390/colloids9010005
APA StyleSánchez-Gaitán, E., González-López, V., & Delgado, F. (2025). Polydispersity and Composition Stability in a Long-Term Follow-Up of Palmarosa (Cymbopogon Martini) and Tea Tree (Melaleuca Alternifolia) O/W Nanoemulsions for Antibacterial Use. Colloids and Interfaces, 9(1), 5. https://doi.org/10.3390/colloids9010005

